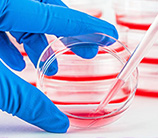
微生物細(xì)胞計(jì)數(shù)-圖像法

Guangzhou BodBoge Technology Co., Ltd. is a national high-tech enterprise integrating research and development, production, and sales. The company specializes in the research and manufacturing of cytological analysis instruments, attaching great importance to the accumulation of independent intellectual property rights.In 2013, the company launched the independently developed fully automatic cell counter and won the "China Innovation Design Red Star Award" in 2014.